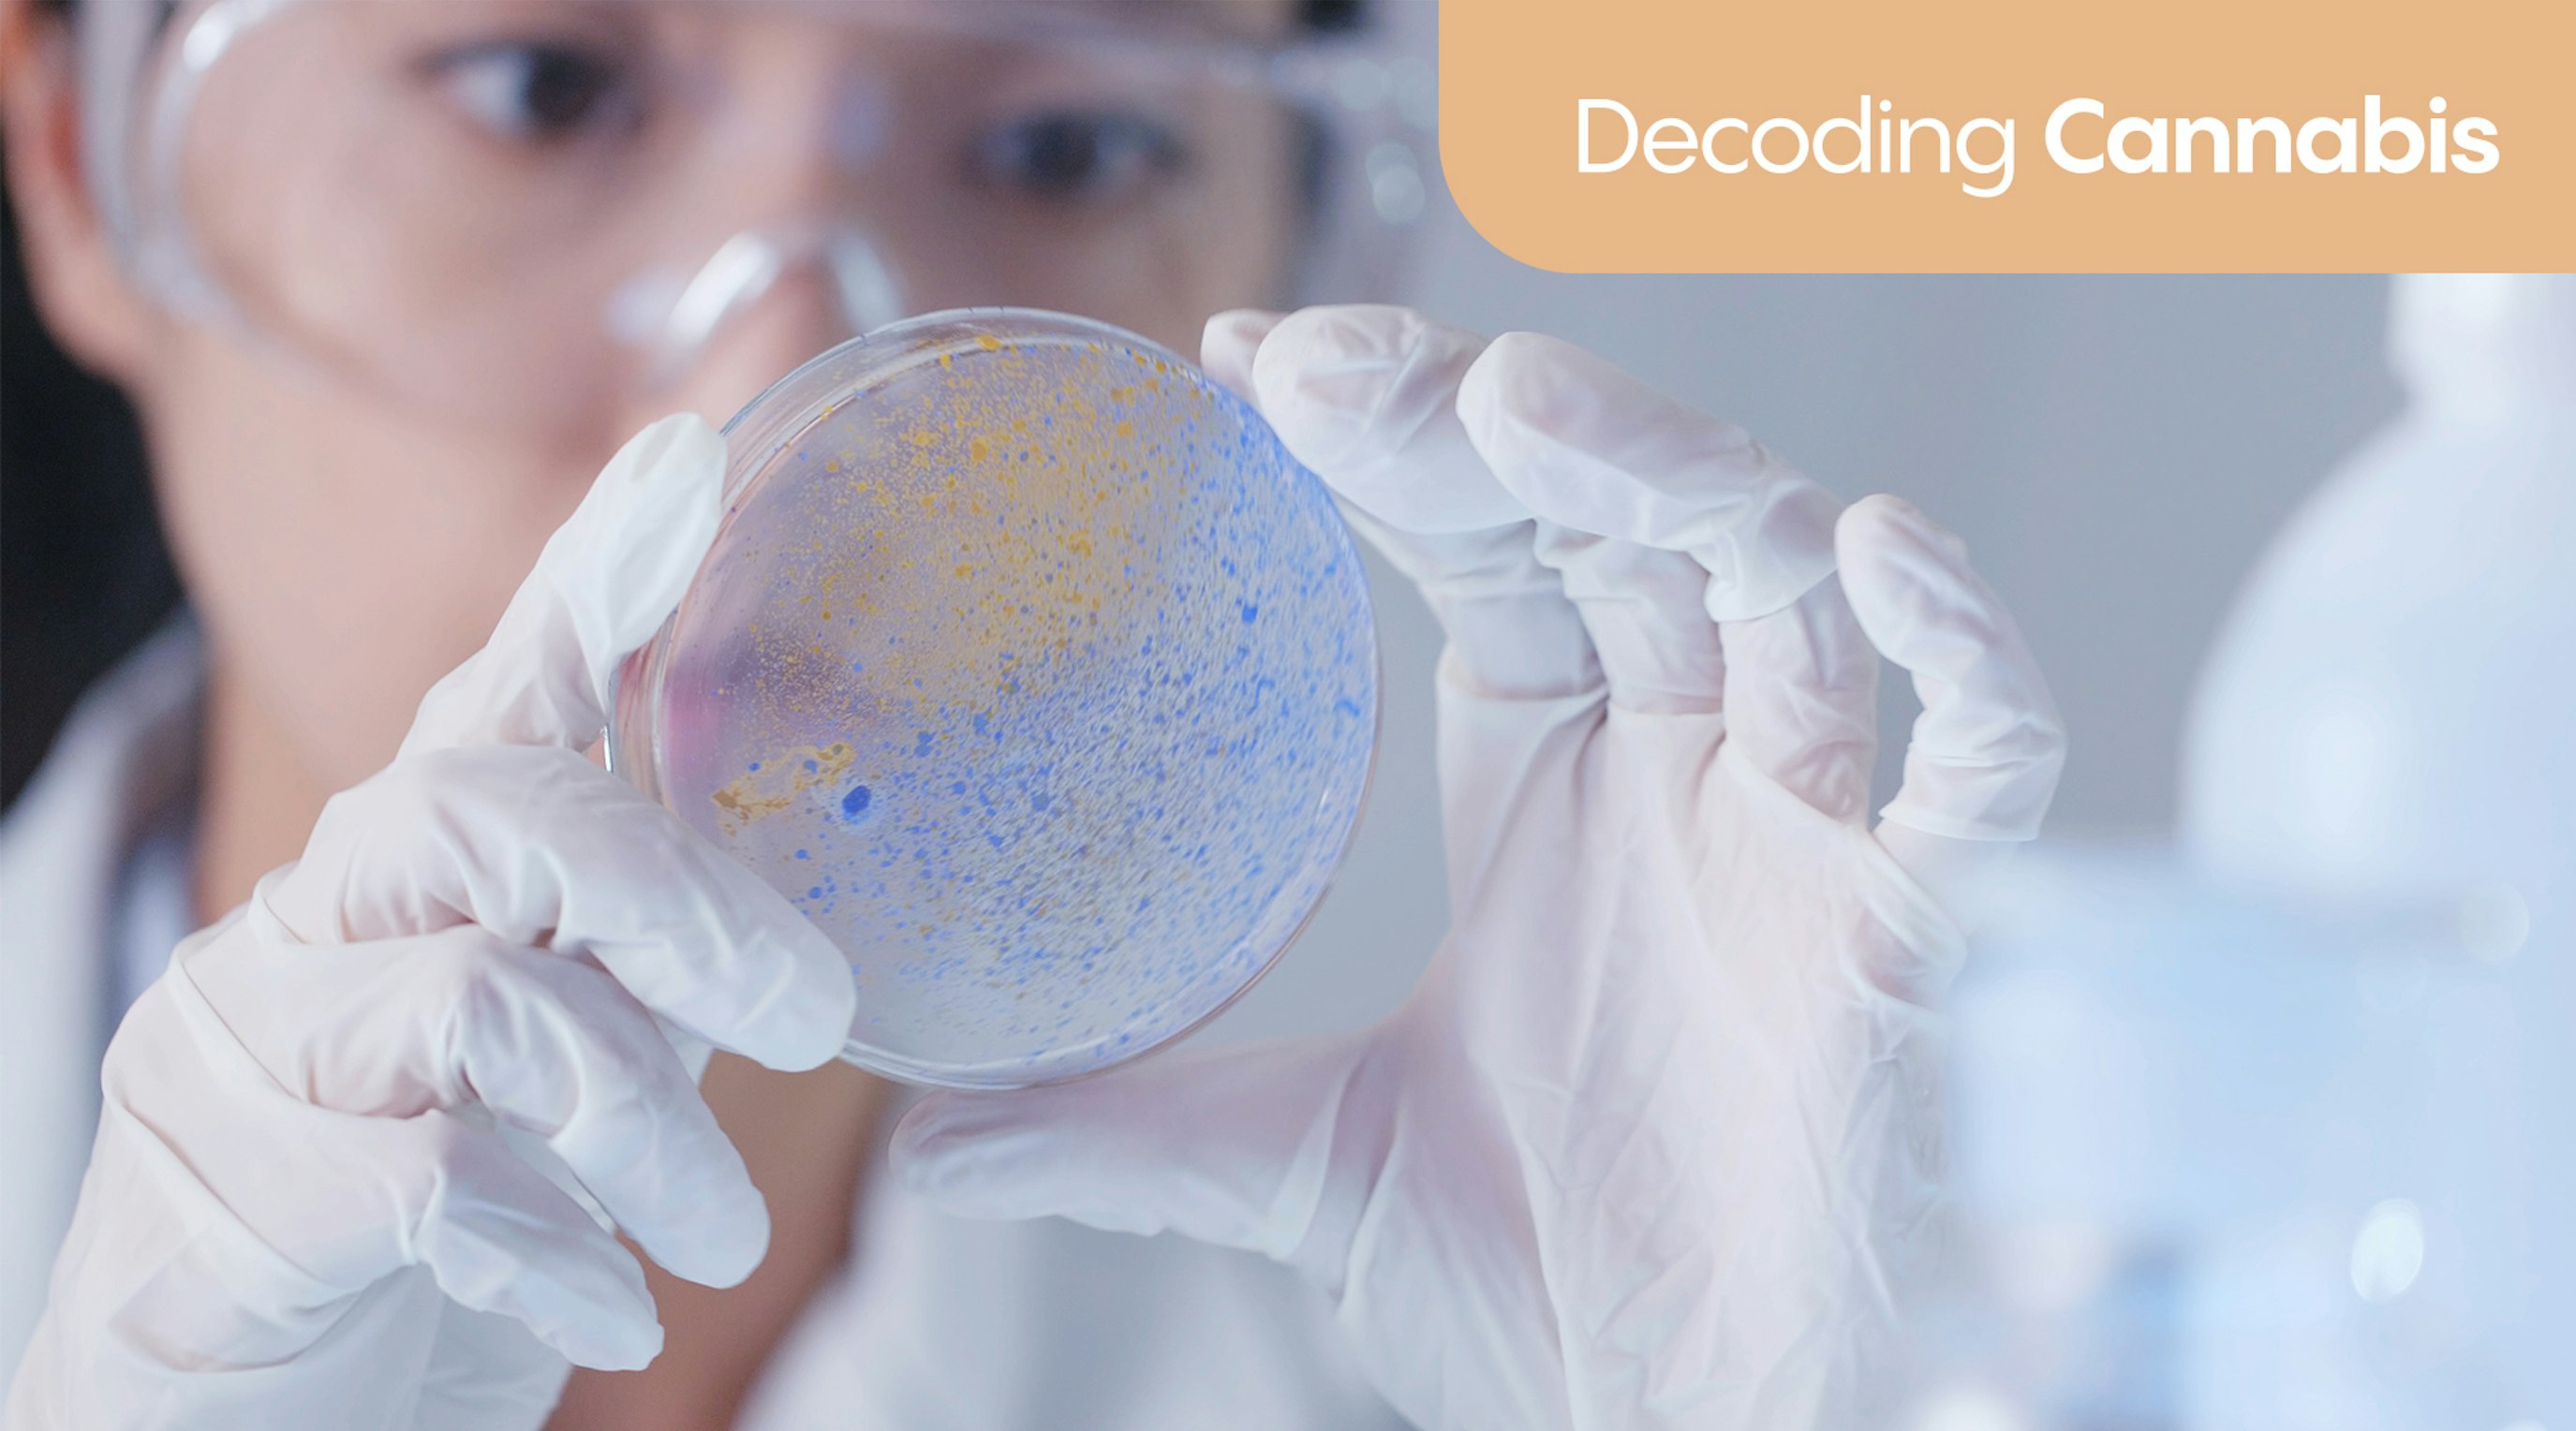
Can cannabinoids help with gut and digestive health? Can cannabinoids help with gut and digestive health?
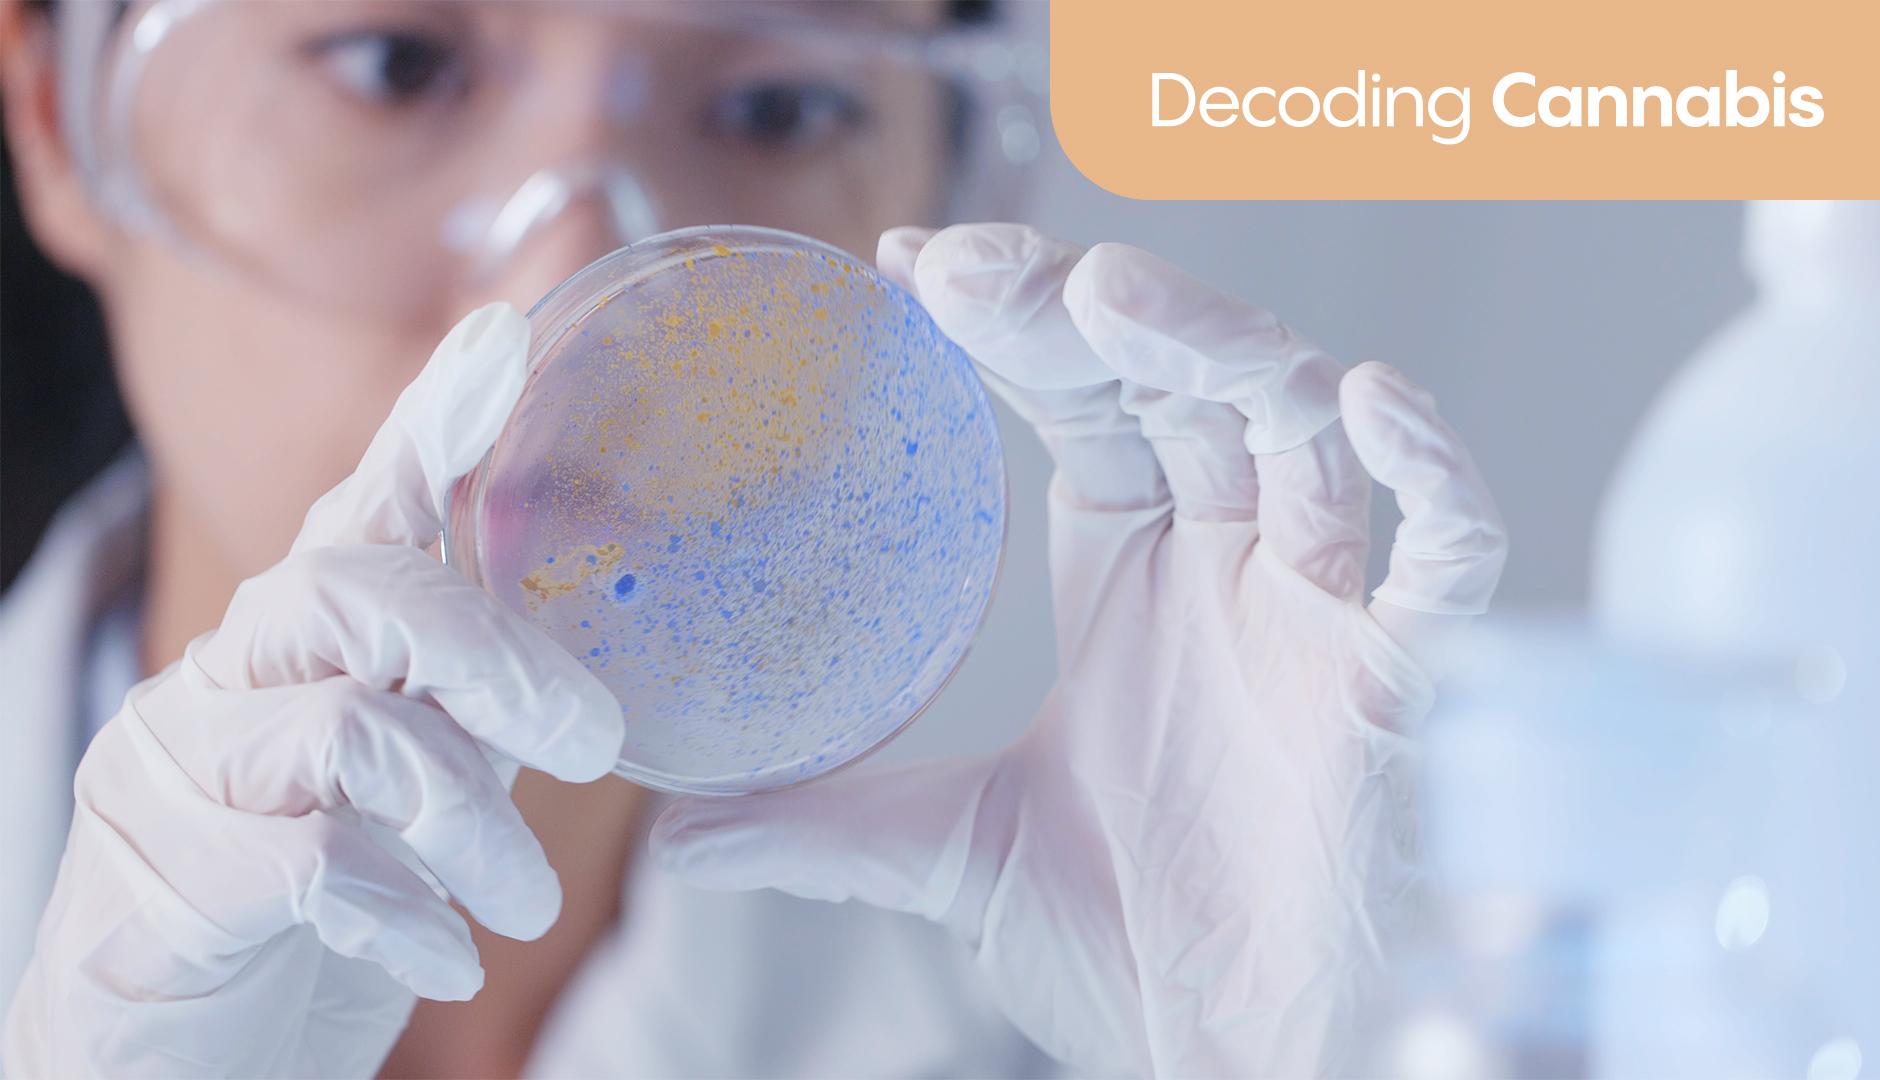
Can cannabinoids help with gut and digestive health?

Decoding Cannabis: Can cannabinoids help with gut and digestive health?
14 min read
Sam North
The gut does far more than digest. It's a second brain of sorts, wired with nerves, hormones, and immune cells, all working in sync with the microbiome. This blog focuses on new research and explores how cannabinoids interact with that system, drawing from one of the most comprehensive clinical reviews to date, along with real experiences from Releaf patients living with chronic GI conditions.
Contents
The gut is astonishing. It’s not just there to digest and absorb, not at all. As the old saying goes, “trust your gut”, our gastroenterological system (sometimes referred to as our second brain, thanks to the ridiculous numbers of neural cells that are found in the GI) signals, adapts, and reacts.
But it speaks its own language, a language we are only just beginning to understand, through nerves, hormones, and the immune system working with the gut microbiome.
When that system is off-kilter, the results can be pretty hard to ignore. For some, it’s nausea that won’t ease. For others, cramps without warning. Bowels that speed up, slow down, or simply refuse to cooperate even when we fell like we are living life ‘right’.
Over the past decade or so, medical cannabis has entered the conversation as a way to help manage these symptoms. It’s not some miracle cure for all GI issues, but as a tool (one that interacts with a system already embedded in the body’s regulatory machinery: the endocannabinoid system), it’s showing some truly fascinating potential.
Welcome back to Decoding Cannabis, our weekly blog series where we take one of the newer pieces of medical cannabis research and lay it all out in slightly more human terms - cutting through the sciencey jargon, while still holding onto the important details.
Today’s study is a clinical review titled “Role of Cannabis and Its Derivatives in Gastrointestinal and Hepatic Disease”, published in Gastroenterology in 2021. It’s one of the most comprehensive overviews available right now, covering everything from nausea and inflammatory bowel disease, to IBS, obesity, fatty liver, and the microbiome.
The endocannabinoid system plays a key role in gut health
Only first identified in the late 1980s, the endocannabinoid system is one of the body’s (and brain’s) most widespread neuromodulator systems. It helps keep things steady, not just in the brain, but across the gut, immune system, and beyond.
It does this through receptors called CB1 and CB2, which respond to cannabinoids the body makes naturally. THC and CBD (cannabis derived cannabinoids) can also interact with these same receptors. In the gut, this system helps control inflammation, gut movement, and pain signalling.
Learn more: Read our quick new patient guide to the endocannabinoid system
Cannabis may relieve symptoms in IBS, but clinical evidence is early
IBS is one of those conditions that wears several masks. For some the main symptom is diarrhoea, for others it’s the total opposite, and for many a strange mix of both (along with cramping, bloating and pain that seems to flare up without much warning).
With such varied symptoms, it is no huge surprise that conventional treatment options are a little hit-and-miss, which goes some way to explaining why so many UK patients have turned to medical cannabis for IBS.
How might cannabinoids affect IBS symptoms?
The gut is packed with cannabinoid receptors. CB1 sits along the nerves that help control how the bowel contracts. CB2 gets more involved when there’s inflammation. Both are active in areas where things go awry in IBS.
Cannabinoids may reduce sensitivity, slow down overactive motility and calm local immune responses. There’s also growing interest in FAAH, an enzyme that clears away your body’s own cannabinoids. Blocking FAAH seems to raise baseline endocannabinoid tone, which (in animal models) can dial down gut hypersensitivity and improve stress-related symptoms.
It’s not one simple mechanism. But the architecture is there, and biologically, it makes sense.
What do patient studies and trials show?
Human data is, unfortunately, a little less clear-cut, thanks largely to the ongoing prohibition of cannabis in far too many countries. Sure, things are slowly shifting, but more than a century of restriction has left the research landscape thin and patchy. What we do have tends to come from small studies, inconsistent dosing, and short timelines.
Thankfully, that’s starting to change, and by the end of the 2020s, we should have a far better idea of how medical cannabis offers such extensive therapeutic potential.
One trial used dronabinol (a synthetic form of THC) and found that it slowed gut transit in people with IBS-D. But it didn’t do much for pain or bloating.
Other studies have looked at genetic differences (variants in FAAH and CNR1) to explain why some patients respond better than others. There’s potential here, but the findings are early and the samples small.
Most research to date has been short-term, underpowered and inconsistent in how the cannabis is administered. That makes conclusions hard to draw. Still, there’s enough signal to say this isn’t a dead end. Just an under-explored one.
Can CBD alone help with IBS?
The available research right now points to a tentative answer of “probably not”, or, at least, not on its own. CBD has been proven to really help reduce rates of inflammation and anxiety, which can play a role in flare-ups. But as a specific gut-targeted treatment, it hasn’t yet delivered strong results.
THC is the main analgesic here. It’s far more potent when it comes to pain suppression, especially the kind triggered by visceral hypersensitivity, a core problem in many IBS cases. For some patients, it’s the combination of THC and CBD that works best, each doing part of the job.
Inflammatory bowel diseases show the strongest clinical potential
Of all the gut conditions where medical cannabis may help control symptoms, Crohn’s disease and ulcerative colitis sit near the top.
These are long-term inflammatory diseases that often refuse to play nicely with standard treatments. For some, cannabis is giving back a little breathing space, less pain, better appetite, fewer toilet dashes.
How does the ECS interact with IBD pathways?
In IBD, the immune system is stuck in overdrive. The endocannabinoid system helps keep it in check, especially through the CB2 receptor, which is busy in the gut’s immune cells when things flare up.
In animal studies, switching off CB1 or CB2 makes the inflammation worse. Turn them on (with medical cannabis treatment), and things tend to calm down. We’ve also seen that certain gene differences in these receptors might help explain why some people respond better than others.
What have real patients with Crohn’s and UC reported?
Releaf patients who have been prescribed medical cannabis for Crohn’s or UC often describe less pain and cramping, fewer urgent trips to the loo, and better sleep. Again, we are not saying that cannabis-based treatment options will cure either condition, but they can help quiet the flare-ups, while also reducing the severity of some of the secondary symptoms like sleep issues and the mental health toll.
To hear directly from patients, keep scrolling. There’s a section further down in this blog where we share real experiences from the Releaf community.
What have clinical trials found so far?
Trials using THC-rich cannabis show that patients feel better with lower pain scores and better overall sleep - but the inflammation, on the whole, sticks around. So in these trials, it’s helping with symptoms, not necessarily switching off the mechanism behind the disease.
Meanwhile, CBD-only trials haven’t lived up to the early hope. Full-spectrum products with both THC and CBD seem to work better, and some newer compounds that target CB2 specifically, like Olorinab, are now being tested.
Cannabis affects nausea, vomiting, and gastric emptying in complex ways
Nausea is one of those symptoms that can quickly ruin a day. No matter if it’s creeping and constant or sudden and severe, waves of feeling like you need to empty your stomach have a way of overriding everything else - appetite, focus, memory, sleep, even sometimes heavy pain.
Cannabis has been taken for centuries to ease nausea and vomiting.
Today, it’s one of the many treatment options available to UK patients going through the heavy side effects of chemotherapy, but only when standard medications aren’t cutting it.
Can cannabinoids help with nausea and emesis?
One of the brain’s most ancient systems for survival is the emetic reflex, more often referred to as the “gag reflex”.
This reflex is controlled partly by the brainstem, but also by the vagus nerve, which runs from the gut to the brain. It’s here that CB1 receptors show up, and it’s here that THC seems to help some people suppress that reflex.
In studies on chemotherapy-induced nausea and vomiting, THC has shown moderate success.
It is not a legal first line treatment, meaning medical cannabis is prescribed for chemotherapy-induced nausea and vomiting only for patients who have tried at least two conventional treatment solutions with little or no success.
What is cannabinoid hyperemesis syndrome (CHS)?
At the other end of the scale is something far less helpful: cannabinoid hyperemesis syndrome. It’s extremely rare, but it does happen, mostly in people who’ve been using high-THC cannabis regularly for long periods without any form of clinical oversight. The symptoms include repeated bouts of vomiting and nausea, often only relieved by hot showers or baths.
Researchers aren’t entirely sure why CHS happens. One theory is that constant activation of CB1 receptors messes with how the gut regulates itself, especially how quickly the stomach empties. Another is that the system becomes desensitised, that the receptors stop working properly after too much stimulation.
Either way, symptoms usually go away when cannabis is stopped completely.
What delivery methods matter most here?
How cannabis is taken makes a difference.
When inhaled (vaporising is the only legal way to inhale medical cannabis in the UK), it works faster and tends to have fewer effects on how the stomach empties. Oral cannabis (oils, capsules, or edibles) takes longer to kick in and might slow digestion even further if used at the wrong time.
Sublingual application, where oil is held under the tongue, strikes a great middle ground. It offers relatively quick onset without passing through the digestive tract, and the absorption rates are much higher than when the oil is swallowed.
Cannabinoids interact with gut motility, sometimes in opposing ways
The cannabinoids offered up by Cannabis sativa L. based treatment options can change gut mobility - sometimes slowing things down, other times easing cramping or spasms. CB1 receptors, when activated, tend to reduce motility. That means food and waste move more slowly. CB2 plays more of a role during inflammation.
This shift in gut movement can be a blessing or a bit of a gamble.
For people with IBS-D or frequent cramping, cannabinoids that slow things down may offer genuine relief. But for those dealing with constipation or gastroparesis, the same effect can backfire. It often comes down to the dose, how it's taken, and the THC to CBD ratio.
Most new medical cannabis patients, especially those totally naive to cannabis, will go through a short period when they first begin treatment where a little experimentation with dose and treatment options is required, before finding the best option for individual health needs.
This is totally normal, and somewhat expected. Your clinical team will guide you through the titration process, and check in regularly to make sure everything is working how it is supposed to.
Cannabis may influence the gut microbiome and inflammation
Beyond digestion, the gut microbiome is one of the body’s most powerful regulators. It shapes our immune responses, keeps inflammation in check, and communicates constantly with the brain.
There’s early evidence that cannabinoids can nudge this ecosystem in subtle but meaningful ways. In animal studies, THC has been shown to shift the balance between major bacterial groups like Firmicutes and Bacteroidetes. Some Lactobacillus strains may even boost CB2 receptor expression — a possible link between the gut’s bacteria and its immune tone.
We’re still very much in the early stages of understanding this relationship. But the foundations are compelling, and they raise new questions about how cannabis-based treatment could affect inflammation at its root.
But it’s early days. We still need placebo-controlled human trials before any firm conclusions can be drawn. That said, the growing body of anecdotal evidence, of patients speaking out on just how much medical cannabis has eased their gut symptoms, is hard to ignore.
While it’s not a substitute for clinical data, these lived experiences are helping shape where research goes next, and who gets access to it.
What Omar shared about managing IBS with Releaf medical cannabis
Omar, 31, is a theatre director living with chronic IBS. After more than a decade of trying everything the NHS could offer, he often found himself stuck at home, missing work, and unable to enjoy life.
When he discovered Releaf, things began to shift:
"It can be quite traumatic to be in that amount of pain for days at a time. If I flare up on holiday, that’s it, I’m stuck in the hotel, not able to go out and enjoy myself. The flower allows me to kind of take the edge off, so things don’t spin out of control. It's something I can take that isn't going to disrupt my day or influence my cognitive functioning.”
"It's the only thing that has allowed me to sleep through the pain at night. The length of time that I’m in pain is shortened from four, five, or six days to one or two days maximum. IBS is very complicated… I needed a medicine that would relax my muscles, but also affect my mood, disassociating me from the pain."
"Medical cannabis has not only helped with my pain, but it’s changed my relationship with my illness. The relationship between the mind and body is an incredibly powerful one."
Final thoughts
The gut is deeply individualised, as is medical cannabis treatment.
Each person’s symptoms, triggers, and response to treatment (both conventional and complementary) can vary wildly, and that’s part of what makes conditions like IBS, Crohn’s, and functional gut disorders so difficult to manage.
Medical cannabis isn’t a magic fix for every single person battling gut issues in the UK, but it can offer therapeutic support to many. What this growing body of research (and lived experience) points to is a powerful tool with multiple effects — pain relief, anti-inflammatory action, improved sleep, reduced anxiety — all of which can play a role in managing chronic gastrointestinal conditions.
There’s more we need to understand. Larger studies, better dosing guidance, and deeper understanding of the endocannabinoid system are all not far over the horizon. But for many patients already taking Releaf prescriptions for gut health, the benefits are more than just theoretical.
If you’re living with a chronic GI condition and wondering whether cannabis-based treatment could help, our fast and free medical cannabis eligibility checker is a good place to start. It only takes a minute, and our world-class clinical team and patient support team are here to support you every step of the way.
Did you like this article?
It is important to seek medical advice before starting any new treatments. The patient advisors at Releaf are available to provide expert advice and support. Alternatively, click here to book a consultation with one of our specialist doctors.